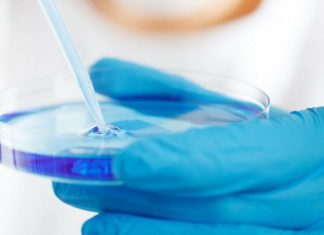
FDA подтверждает и одобряет новую генную терапию

Поддержание нормального состояния рабочего пчелиного улья становится возможным только в том случае, когда речь идет о возможности быстрого и качественного обнаружения так называемых пиретроидов – специальных пестицидов, уничтожающих большую часть рабочих пчел и оставляющих в живых лишь пчелу-королеву вместе с ограниченным количеством пчел. Обычно быстро обнаружить такой тип пестицидов бывает крайне сложно, поскольку он нередко скрывается под довольно большим количеством схожих симптомов, однако сегодня талантливая команда исследователей из Канадского Университета Ватерлоо представила новый способ такого обнаружения пестицидов и их уничтожение.
Стандартные и традиционные способы обнаружения такого рода пестицидов-загрязнителей в пчелиных ульях заключаются в применении специальных растворов на основе воды, где пиретроиды могут обнаруживать себя, будучи помещенными в этот раствор – однако такой подход отличается действительно большим количеством проблемным моментов, поскольку, во-первых, не всегда можно изготовить такой раствор из подручных средств, ввиду его относительной химической сложности, а во-вторых, необходимо тратить на это довольно приличное количество времени, за которое большая часть пчелиного улья может исчезнуть.

Вместо этого канадские исследователи предложили еще более простое и быстрое решение – использовать алкоголь и растворы на его основе, поскольку именно алкоголь лучше всего устраняет пестициды широкого профиля, в том числе и пиретроиды. Проведя несколько предварительных тестирований и исследований на этот счет, оказалось, что они в самом деле сумели добиться более быстрого способа обнаружения пестицидов.
Разумеется, пока еще рано говорить о сколь-нибудь быстром и точном подходе к коммерциализации данного вида растворов и подхода в целом, однако можно точно отметить, что поиск и идентификация новых способов сохранения пчелиных ульев является одним из наиболее приоритетных аспектов и задач в современной биологической науке, поскольку мировая популяция пчел с каждым годом продолжает стремительно падать, что не может не вызывать определенные опасения у исследователей и простых людей, работающих с этими насекомыми.